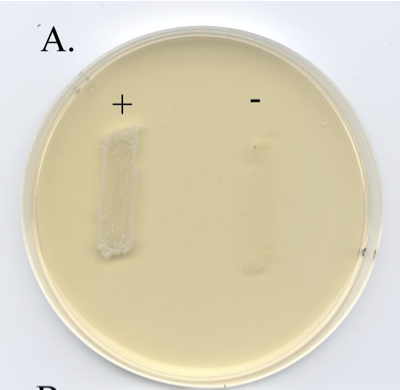
<p><span><span>PEA Agar with growth of Gram +ve organism (left) and Gram –ve organism (right) with inhibited growth.</span></span></p>
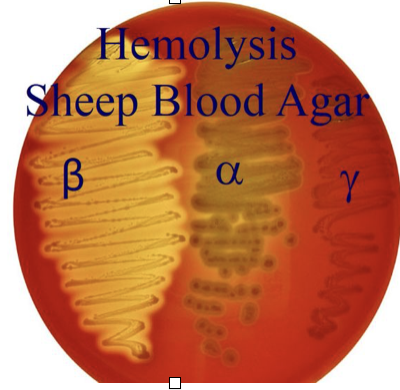
<p>complete breakdown of the RBCs and is recognized by clearing around the colonies</p>
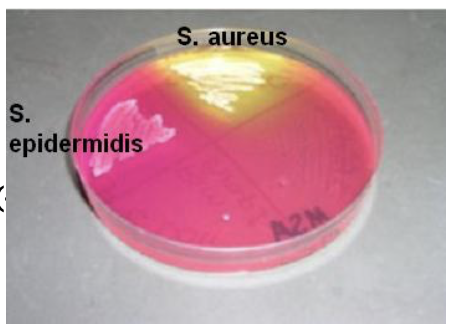
<p>Yellow indicates mannitol positive (+). No color change indicates mannitol negative (-)</p>

Selective and Differential Media
1/13
There's no tags or description
Looks like no tags are added yet.
Name | Mastery | Learn | Test | Matching | Spaced | Call with Kai |
|---|
No analytics yet
Send a link to your students to track their progress
14 Terms
Selective media..
allow certain types of organisms to grow and inhibit the growth of other organisms (a particular selective agent can inhibit gram-negative bacteria while promoting the growth of gram-positive bacteria)
Differential media..
are used to differentiate closely related organisms or groups of organisms (useful in differentiating bacteria according to some biochemical characteristics)
Examples of selective media include…
eosin methylene blue agar, mannitol salt sugar, macconkey agar, and blood agar
Examples of differential media include…
Eosin Methylene blue agar, Mannitol salt sugar, MacConkey Agar, and Blood Agar
Phenylethyl Alcohol (PEA) Agar
Selective medium for the isolation of gram-positive organisms and inhibits growth of gram-negative organisms
How does it inhibit growth gram -ve bacteria?
Phenylethyl alcohol acts to disrupt the lipid structure in the membrane of gram-negyative allowing influx of otherwise blocket molecules and allowing leackage of cellular potassium, thus interfering with DNA synthesis
Plate A
PEA Agar with growth of Gram +ve organism (left) and Gram –ve organism (right) with inhibited growth.
Columbia CNA with 5% Sheep Blood Agar
Differential media of gram-positive organisms based on hemolytic reaction. Selective media against gram-negative organisms due to antibiotics colistin and nalidixic (CNA)
Hemolysis…
the destruction of red blood cells (erythrocytes)
Beta (B) hemolysis is…
complete breakdown of the RBCs and is recognized by clearing around the colonies
Gamma (y) hemolysis…
causes no damage to RBCs and no change in the medium

Mannitol Salt Agar (MSA)
Selective media for halophilic bacteria (staphylococci). 7.5% NaCl, MSA contains high concentrations of salt. Differential media with respect to mannitol fermentation. Contains the sugar mannitol and the pH indicator phenol red
Mannitol Salt Agar (MSA)
Yellow indicates mannitol positive (+). No color change indicates mannitol negative (-)
Eosin Methylene Blue (EMB) Agar
Selective media for gram-negative species and inhibit gram-positive organisms. Differential media with respect to lactose fermentation.